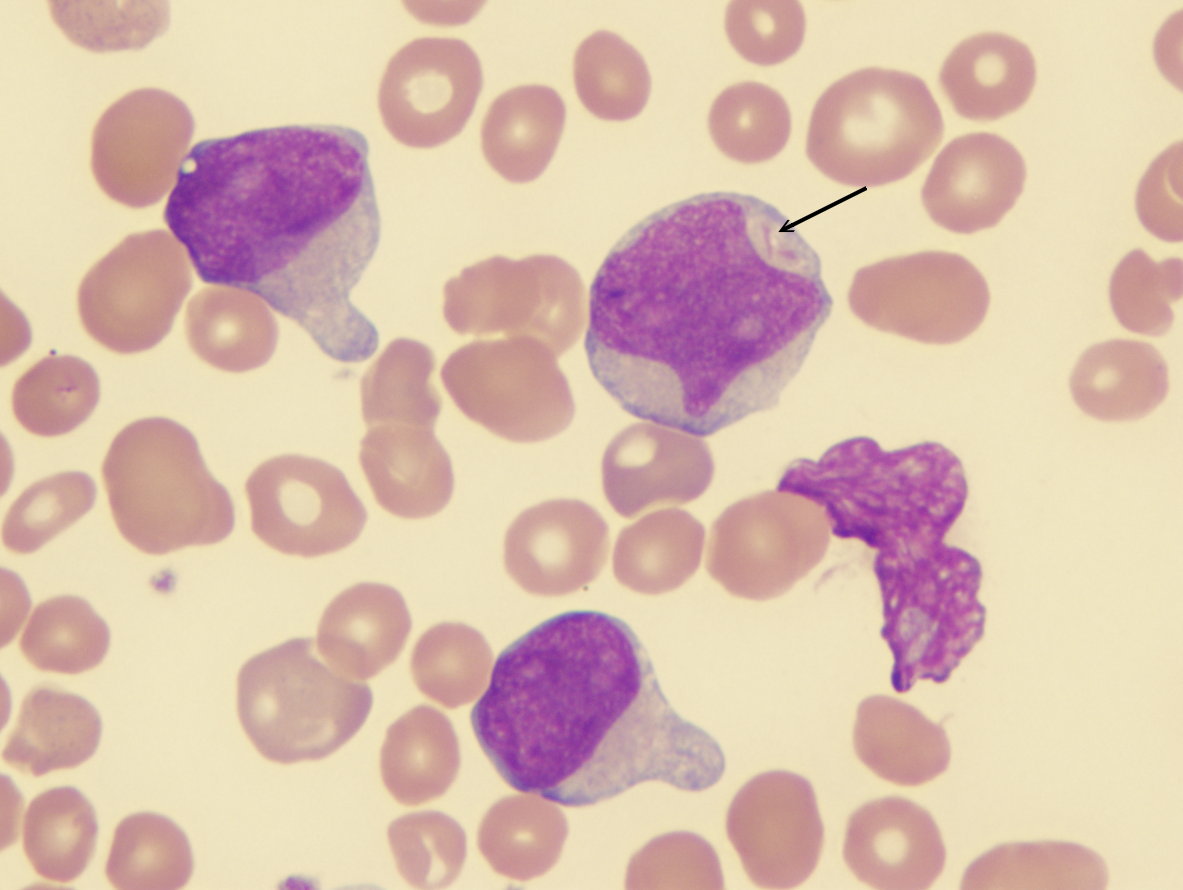

Типы бластов
Клонировать ssd на другой ssd
Стратегии 2025 года на пк
23 декабря этот день в истории
Джаз одесса танцы видео
Мамаева охота
Мутация f2 и f5
Mau 3
Я не хочу быть хорошей женой
Дром камаз кызыле
Правила окончаний множественного числа в английском языке
Отель рамада в аджмане отзывы
Телефон 88005555550
Zombie wars на андроид
Типы бластов 111 фото